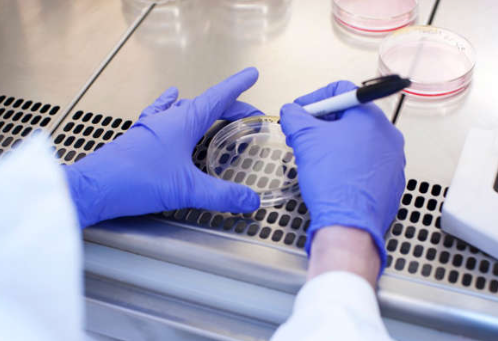
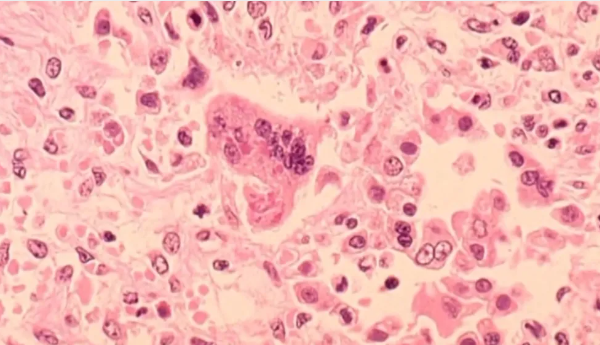

首页 > 国际 > 神秘疾病爆发! 已143死! 症状似流感 传播途径未知 致死率高! 多国机场筛查! 北美惊现不明病例
 收藏
收藏神秘疾病爆发! 已143死! 症状似流感 传播途径未知 致死率高! 多国机场筛查! 北美惊现不明病例
![加西周末]() 加西周末 2024-12-16 09:22
加西周末 2024-12-16 09:22
一场堪称人类浩劫的新冠疫情过去,整个世界乱套后重整,至今尚未完全复原,让人类意识到了病毒的可怕。世界卫生组织才发出警告,说比新冠疫情更加严重的流行病随时可能袭来,并将这种未知病原体引起的疾病称为“X疾病”(Disease X)。
“未知的病原体可能会使世界面临比新冠还严重20倍的疫情”。
没想到,话才说完没几个月,“X疾病”就真的来了。

最近,刚果民主共和国突然爆出未知病原体疫情,仅11月就死了至少143人!至少500人出现症状!

虽然集中爆发是在11月,但卫生部门是在这个月才报告的,大批感染者出现类似流感的症状,包括高烧、咳嗽、流涕、贫血、严重头痛等。
妇女和儿童受影响最为严重,143名死者中很多都是儿童。
问题就在于,现在这种疾病的病原体还未知。
也就是说,就连它是细菌还是病毒都还不确定,无从对症下药,只知道从症状来看,这可能是一种呼吸道疾病。

(CNN资料画面,仅示意)
由于刚果医疗条件极差,病原体又不明,感染者得不到治疗,很多人都直接病死在家中,所以真实死亡数字很可能超过143人。
国内爆发不明疫情,刚果当局立即上报了,非洲疾控中心(Africa CDC)和世卫组织纷纷紧急发出了警告,与当地的卫生部门开展调查。

世卫组织已经派出专家前往爆疫地区,提供基本药物和诊断试剂盒,帮助分析疾病的原因。
然而,到现在为止还是没有找到病原体,就连传播方式都不知道。
根据世卫组织的最新通报,部分感染者还被检测出来患有疟疾。

12月10日,世卫组织通报了已知信息,儿童受影响最严重,0-14岁儿童占了所有报告病例的64.3%;死亡病例的71%年龄都在15岁以下。
感染死亡病例主要出现的症状包括呼吸困难、贫血和急性营养不良等。
虽然现在还不确定,但专家们指出,如果是复合型的多种疾病,情况就会变得非常棘手。

现阶段来说,世卫组织还表示这个未知疫情的全球风险还“较低”,暂时没有扩散到其他国家的迹象,但有已传播到邻国的风险。即便现在关于这个“X疾病”的相关信息还不多,但经历过新冠惨痛教训的人们已经亮起了警报灯,就怕历史重演,已经接连有多个国家开始预防性筛查了。

意大利卫生当局已决定在机场加强对来自刚果乘客的检查,防范“未知疾病输入”;
中国香港和澳门卫生当局也发布公告,表示密切关注此事,且加强对非洲几个重要中转地抵港乘客的健康检查;

此外,洪都拉斯、泰国等国也都发布声明,正在加强机场监控;日本直接警告国民,建议不要前往刚果(金)进行“一切不必要的旅行”。
美国俄亥俄州发现了一名患有不明呼吸道疾病的非洲旅客,正在紧急隔离中。

这边非洲的“X疾病”疫情还不明朗,可能还暗藏着危机,南半球又爆出“重大生物安全漏洞”!
近日,澳大利亚昆士兰州政府自爆,说当地一个实验室弄丢了“超过数百个知名病毒样本”!卫生局正在针对这起事件展开调查。

捅了大娄子的是昆士兰公共卫生病毒学实验室,被爆出323个多种传染性病毒的样本遗失,包括亨德拉病毒(Hendra virus)、丽沙病毒(Lyssavirus)及汉他病毒(Hantavirus)。

目前,当局也搞不清楚这些病毒样本究竟是被盗、还是被销毁。
美国生命科学专家萨姆·斯卡皮诺博士(Sam Scarpino)表示,这在国际上属于“严重生物安全失误”,这三种病原体在人类中的致死率非常高。
本周五,加拿大多伦多皮尔逊机场爆“高传染性”病毒,卫生局立即发警告通知所有旅客自检:出现症状不要上班、上学!

据悉,此次是因为多伦多皮尔逊机场及土耳其航空公司的两架飞机出现了麻疹病例,全部有可能接触到病毒的旅客,都需要自我检测观察。
卫生局证实,12月10日,皮尔区确诊了一例一例麻疹病例,患者有“近期有国际旅行史”,曾在12月4日从土耳其飞抵多伦多。
12月4日搭乘土耳其航空TK707航班从喀布尔飞往伊斯坦布尔、以及同天搭乘TK17航班从伊斯坦布尔飞往多伦多的所有乘客,都可能接触过麻疹病毒!

除此之外,12月4日晚上6点45分至10点30分期间去过皮尔逊机场1号航站楼的任何人,也可能接触过麻疹患者!
麻疹属于高度传染性的病毒,会传播给未接种疫苗或感染过麻疹的人。
通常情况下,麻疹患者会在感染1至3周后出现症状,,包括高烧、流鼻涕、咳嗽、眼睛红肿流泪、对光敏感,还伴随持续4至7天的红色皮疹。

出现任何症状的麻疹病毒潜在接触者,请立即联系医院,不要上班上学!
截止12月4日,安大略省今年的麻疹病例总数达到35例,是去年全年的7倍多,其中7人需住院治疗。
2024年迄今为止,加拿大全国6个省份报告了138例麻疹病例,比去年飙增11倍,也2015年以来病例数最多的一年。
本文为转载发布,仅代表原作者或原平台态度,不代表我方观点。澳洲印象仅提供信息发布平台,文章或有适当删改。对转载有异议和删稿要求的原著方,可联络 [email protected]
 收藏
收藏

你需要登录后才能评论 登录